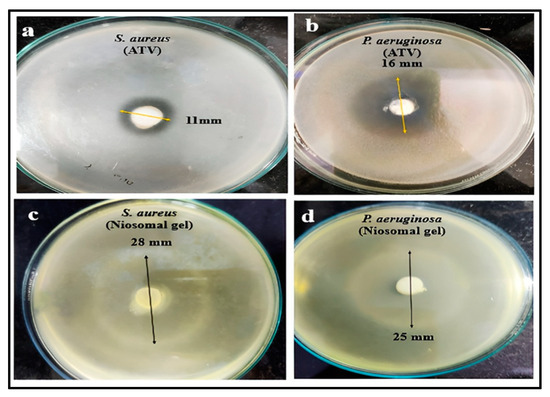

Abstract
Nowadays, smoking and tobacco-related habits (chewing tobacco) are recognized as the most frequent environmental risk factor for periodontal disorders. Atorvastatin calcium (ATV) is a well-known lipid-lowering drug, but recent studies have discussed its pleiotropic effects, including anti-inflammatory properties, anti-bacterial properties, etc. This anti-inflammatory effect can be studied as an adjunct for scaling and root planing (a non-surgical process to remove dental tartar and smooth root surfaces) for periodontic problems. The goal of the study is to formulate and evaluate ATV-niosomes, introduce them in a gel-based formulation by utilizing an appropriate gelling agent, and evaluate them for various parameters. The niosomal vesicles were prepared using the thin-film hydration method. Gel was prepared using the dispersion method, and an in vitro drug release study was conducted using a Franz diffusion cell. According to the results evaluated, ATV niosomal gels loaded with different concentrations of Carbopol 934 were effectively produced utilizing ATV-niosomes that were formulated through the thin-film hydration process using cholesterol and Span 60. The ATV-niosomes showed the highest entrapment efficiency, up to 84%, and the zeta potential (−18 mV) and PDI (0.106) showed stable and homogenous behavior in the vesicles formed. The performance of the optimized gel containing 1% Carbopol 934 showed in vitro release of up to 8 h following zero-order release. The gel also proved to have antimicrobial activity against S. aureus and P. aeruginosa. Therefore, we conclude that 1% Carbopol 934 gel comprising ATV-niosomes showed a prolonged effect compared to plain ATV and can effectively work to improve the periodontal condition as an adjunct to scaling and root planing.
1. Introduction
Chronic periodontitis (CP) is a condition of inflammation with a microbial origin that predominantly affects the tissues that support the teeth and causes the periodontal ligament and alveolar bone to gradually deteriorate [1]. Statins influence the inflammatory response, immunological response, bone metabolism, and bacterial clearance through several different routes. They primarily achieve this through the ERK, MAPK, PI3-Akt, and NF-κB pathways, which promote the production of anti-inflammatory and/or pro-resolution molecules while inhibiting the release of proinflammatory cytokines. Additionally, they can control the host reaction brought on by the bacterial challenge, stop inflammation-mediated bone resorption, and encourage bone growth [2].
Atorvastatin calcium (ATV) is highly known for its anti-hyperlipidemic activity, but according to several studies, it has also proved to have good anti-inflammatory properties against periodontitis, along with improving bone density [3,4]. Furthermore, it prevents the disease from getting worse by reducing bacterial growth, compromising the stability of bacterial membranes, and enhancing bacterial clearance. In comparison to systemic delivery, local statin administration as an adjuvant to both nonsurgical and surgical periodontal therapy leads to superior periodontal treatment outcomes [5]. According to several clinical studies, including [3,4,6], atorvastatin calcium (ATV) has proved to have good anti-inflammatory properties for periodontal disease.
Niosomes are a new vesicular drug delivery technology that can be employed for prolonged, regulated, and targeted drug administration. Because niosomes are composed of non-ionic surfactants and cholesterol, they are non-toxic. Niosomes are self-assembling vesicles made up of non-ionic surfactants in which the drug is encapsulated. The main features of niosomes are their polar head and hydrophobic tail. They self-assemble by forming two domains through external energy such as heat, agitation, or both. They have an aqueous center and a lipophilic domain which is formed due to their hydrophobic tail. Due to their structure, they can be used to load and distribute hydrophilic and hydrophobic drugs. Niosomes can help increase the oral bioavailability of poorly soluble drugs, in this case, atorvastatin calcium [5,6,7,8,9,10].
A niosomal gel will help with patient compliance and can prevent problems with gastrointestinal drug absorption brought on by stomach pH. Additionally, gels can prevent drug interactions and enzymatic activity with meals and beverages. When the oral route is inappropriate, local oral administration of drugs in the form of gel can increase compliance [11].
This study aims to develop and evaluate a niosomal gel containing atorvastatin calcium for periodontitis by studying the ability of atorvastatin calcium to aid periodontitis. Oral gel formulations will aid in patient compliance by providing easy application and potentially providing targeted and localized treatment of the affected areas. Dental oral gels can be used in conjunction with professional dental treatments such as scaling and root planing (deep cleaning).
2. Materials and Methods
Atorvastatin calcium was received as a gift sample from Micro Labs Pvt. Ltd., Mumbai, Maharashtra, India. Cholesterol, Tween 80, Span 60, Carbopol 934, dichloromethane, triethanolamine, and propylene glycol were purchased from Research-Lab Fine Chem Industries, Mumbai, Maharashtra, India.
2.1. Preparation of Niosomes Loaded with Atorvastatin Calcium
The process of thin-film hydration (Figure 1), also known as the hand-shaking method, is frequently used to prepare niosomes. The drug, non-ionic surfactant, and cholesterol are combined with an organic solvent, here dichloromethane, in a round bottom flask to make niosomes in this manner. A rotating vacuum evaporator (SuperfitRotavap- PBU 6D) is then used to evaporate the organic solvent. A thin layer develops on the interior surface of the round-bottom flask during evaporation. The thin layer is then hydrated at a temperature greater than the surfactant’s transition temperature. In this case, a phosphate buffer solution (PBS) of pH 7.4 was used for hydration. Hydration causes the layer to swell and the drug-containing vesicles to form [11,12,13,14]. Different concentrations of cholesterol and non-ionic surfactant were used to prepare different batches of niosomes (Table 1).

Figure 1.
Schematic representation of the thin film hydration method.

Table 1.
Formulation table for ATV-niosomal formulations.
The prepared niosomes were optimized using parameters such as entrapment efficiency (EE), TEM analysis, the polydispersity index, and zeta potential. An optimized niosomal formulation was used for further characterization [15,16].
2.2. Preparation of Nanogel Loaded with Atorvastatin Calcium Niosomes
- Gel was prepared using the dispersion method. Carbopol 934 was progressively introduced into distilled water to fully hydrate and allowed to stay for 24 h. For the niosomal gel, the optimized loaded niosome was gradually added to the hydrated Carbopol 934 on a magnetic stirrer (REMI 1MLH) along with propylene glycol, resulting in a final concentration of 1.2% (w/w) of atorvastatin calcium niosomal gel. The produced gel’s pH was then measured and adjusted to pH 6–7 using triethanolamine and the final weight was adjusted using distilled water. Various batches of gel were prepared (Table 2) by varying the Carbopol concentration (0.5–2.0%) [17,18].
 Table 2. Formulation table of the atorvastatin calcium loaded niosomal gel.
Table 2. Formulation table of the atorvastatin calcium loaded niosomal gel.
- The optimized niosomal gel was evaluated for homogeneity, grittiness, pH, viscosity, spreadability, extrudability, drug content, drug deposition, and in vitro studies [17,18,19], and an anti-microbial study was conducted against S. aureus and P. aeruginosa using the agar well diffusion method [20,21].
2.3. Determination of %Entrapment Efficiency of ATV-Niosomes
The amount of atorvastatin calcium entrapped in niosomes was determined by the indirect method using centrifugation. A total of 5 mL of niosomal suspension was placed in a centrifugation tube and centrifuged at 10,000 RPM for 10 min at 4 °C. The entrapped amount of atorvastatin calcium in niosomes was determined after separating non-entrapped drug from the supernatant. Then, 1ml of supernatant was dissolved in methanol and serial dilutions followed by filtration were performed. The prepared dilutions were analyzed spectrophotometrically using a UV-Vis double beam spectrophotometer at 244 nm. Entrapment efficiency is defined as the percentage of drug trapped in the vesicle. It is determined following Equation (1) [15].
2.4. Drug Content of ATV-Niosomal Nanogel
A total of 1 gm of each gel preparation was dissolved in methanol (10 mL) using bath sonication. This sample was then subjected to centrifugation. Then, 1 mL from the supernatant was used for serial dilutions to create different concentrations. Following filtration, absorbances were measured at 244 nm. Drug content was determined using the calibration curve and the linearity equation [22].
2.5. Drug Deposition Study of ATV-Niosomal Nanogel
The drug deposited on the oral mucosa was calculated. After a 24 h diffusion study, the oral mucosal membrane was taken out and carefully washed with distilled water for 10 s to remove the gel formulation that had adhered to it. The drug was then removed from the mucosa by sonicating it for 30 min in 10 mL of methanol. Suitable dilutions were carried out following filtration. The amount of atorvastatin calcium was then measured spectrophotometrically in methanol using a UV-Vis spectrophotometer [23].
3. Results and Discussion
UV spectrophotometry was used for the determination of λmax and the plotting of the calibration curve of the drug in methanol and in phosphate buffer of pH 7.4. The compatibility between the drug and the excipients was evaluated using the FTIR method, which showed no interaction between the excipients and the drug (Figure 2).

Figure 2.
FTIR spectra for ATV-niosomal gel.
3.1. Characterization of Niosomes Loaded with Atorvastatin Calcium
3.1.1. Entrapment Efficiency
The entrapment efficiency was in the range of 84–42%, with NF1 having the maximum entrapment efficiency of 84.18 ± 1.45%.
3.1.2. Transmission Electron Microscopy (TEM)
The TEM image (Figure 3) of niosomal vesicles shows particle sizes from 100–300 nm.

Figure 3.
TEM image of niosomal vesicles.
3.1.3. Zeta Potential
The zeta potential of the NF1 formulation was calculated using a Malvern zeta-sizer (Malvern ZS 3000, Malvern Instrument Ltd., Worcestershire, UK). The niosomes’ zeta potential was discovered to be −18.7 ± 5.46 mV (Figure 4a), indicating that the formulation was stable.

Figure 4.
(a) Zeta potential and (b) particle size and PDI of optimized niosomal gel.
3.1.4. Size Distribution and Polydispersity Index (PDI)
The average size of the niosome was found to be 234 ± 37.8 d. nm and the PDI was found to be 0.106 (Figure 4b).
3.2. Characterization of Nanogel Loaded with Atorvastatin Calcium Niosomes
3.2.1. Homogeneity and Grittiness
The homogeneity and grittiness of NF1G2 were better than the other formulation; under an optical microscope, no apparent particulate matter was found in NF1G2. As a result, it meets the criteria of being free of particle matter.
3.2.2. pH Determination
The pH of all formulated gels was found to be in the range of pH 7.1–7.4, indicating all formulations to be near neutral pH (Table 3).

Table 3.
Results of evaluation of ATV-niosomal gel.
3.2.3. Viscosity
The viscosity of the niosomal gel was evaluated using a Brookfield viscometer (DV2T model) with a Helipath spindle T series (D94). NF1G2 showed appropriate viscosity as compared to NF1G1, which was less viscous, and NF1G3 and NF1G4, which were highly viscous (Table 3).
3.2.4. Spreadability
The term spreadability refers to how quickly the gel spreads when a small amount of shear is applied. The spreadability of NF1G1 and NF1G2 was found to be better (Table 3).
3.2.5. Extrudability
The amount of gel that is extruded through the tube’s opening when pressure is applied was used to gauge extrudability. The extrudability of NF1G2 gel was found to be better as compared to other formulations (Table 3).
3.2.6. Drug Content
The drug content of NF1G2 was found to be the highest (86.13 ± 6.31%) as compared to other gels prepared. The drug content was found to be in the range of 69% to 86% (Table 3).
3.2.7. Drug Deposition
The amount of drug deposited after 24 h of diffusion on the oral mucosal layer was found to be lowest for NF1G2, i.e., 17.23 ± 3.52%, indicating that 82.77 ± 5.49% of the drug was released during the diffusion. Thus, NF1G2 is better than other formulations.
3.2.8. Anti-Microbial Study
Antimicrobial activity was estimated by measuring the zone of inhibition of the optimized niosomal gel (NF1G2) against S. aureus (ATCC 6538) and P. aeruginosa (ATCC 27853), which are also responsible factors in periodontitis and were procured from NCIM. The zone of inhibition for S. aureus treated with pure atorvastatin calcium and ATV-niosomal gel was found to be 11 ± 0.16 mm (Figure 5a) and 28 ± 0.48 mm (Figure 5c), respectively, and the zone of inhibition for P. aeruginosa treated withpure atorvastatin calcium and ATV-niosomal gel was found to be 16 ± 0.27 mm (Figure 5b) and 25 ± 0.34 mm (Figure 5d), respectively, indicating that gel works more effectively than pure atorvastatin calcium.
Figure 5.
Invitro antimicrobial activity; (a) S. aureus (ATV), (b) P. aeruginosa (ATV), (c) S. aureus (niosomal gel), (d) P. aeruginosa (niosomal gel).
3.2.9. In Vitro Diffusion and Kinetic Modelling
The NF1G2 formulation showed a maximum drug diffusion up to 83.04 ± 6.04% at 7 h. The kinetic studies interpret that the NF1G2 formulation follows a zero-order model (Figure 6).

Figure 6.
Zero-order kinetic model of optimized ATV-niosomal gel.
3.2.10. Stability Studies
The optimized niosomal gel formulation (NF1G2) was stored at 40 ± 2 °C and 75% RH in a stability chamber for 90 days. The sample was withdrawn periodically and evaluated for pH and precent drug content; in vitro drug diffusion was found to be optimum and satisfactory and there was no significant change in the formulation (Figure 7).

Figure 7.
Stability studies of optimized ATV-niosomal gel.
4. Conclusions
The ATV-niosome showed the highest entrapment efficiency, up to 84.18 ± 1.45%. The niosomes’ zeta potential was −18.7 ± 5.46 mV and its PDI was 0.106, indicating that the formulation was stable. The drug content of the niosomal gel was found to be 86.65 ± 6.31%. The desired results were obtained with 1% Carbopol 934 niosomal gel, which demonstrated in vitro release for up to 7 h and followed a zero-order kinetic model. Anti-microbial activity against strains such as S. aureus and P. aeruginosa, which contribute to periodontitis, indicates that ATV-niosomal gel can be used for inflammatory periodontal conditions. The niosomal formulation may be more successful than other conventional formulations used in periodontal problems, as it may reduce symptoms faster and has enormous potential for future therapeutic applications.
Author Contributions
Conceptualization, B.R.R. and N.S.K.; methodology, B.R.R. and N.S.K.; software, B.R.R. and N.S.K.; formal analysis, B.R.R. and N.S.K.; investigation, B.R.R. and N.S.K.; resources, B.R.R. and A.S.J.; data curation, N.S.K. and B.R.R.; writing—original draft preparation, B.R.R. and N.S.K.; writing—review and editing, N.S.K., B.R.R. and A.S.J.; visualization, B.R.R. and A.S.J.; supervision, A.S.J. All authors have read and agreed to the published version of the manuscript.
Funding
This research received no external funding.
Institutional Review Board Statement
Not applicable.
Informed Consent Statement
Not applicable.
Data Availability Statement
Data are contained within the article.
Acknowledgments
This work is fortified by Shri D.D. Vispute College of Pharmacy and Research Center, Panvel, India.
Conflicts of Interest
The authors declare no conflict of interest.
References
- Shirke, P.Y.; Kolte, A.P.; Kolte, R.A.; Bawanakar, P.V. Evaluation of the Clinical Efficacy of 1.2% Atorvastatin in the Treatment of Periodontal Intraosseous Defects by CBCT: A Randomized Controlled Clinical Trial. J. Dent. Res. Dent. Clin. Dent. Prospects 2019, 13, 183–191. [Google Scholar] [CrossRef] [PubMed]
- Petit, C.; Batool, F.; Bugueno, I.M.; Schwinté, P.; Benkirane-Jessel, N.; Huck, O. Contribution of Statins towards Periodontal Treatment: A Review. Mediators Inflamm. 2019, 2019, 6367402. [Google Scholar] [CrossRef] [PubMed]
- Martande, S.S.; Kumari, M.; Pradeep, A.R.; Pal Singh, S.; Kumar Suke, D. Comparative Evaluation of Efficacy of Sub gingivally Delivered 1.2% Atorvastatin and 1.2% Simvastatin in the Treatment of Intrabony Defects in Chronic Periodontitis: A Randomized Controlled Trial. J. Dent. Res. Dent. Clin. Dent. Prospects 2017, 11, 18–25. [Google Scholar] [CrossRef] [PubMed][Green Version]
- Kumari, M.; Martande, S.S.; Pradeep, A.R.; Naik, S.B. Efficacy of Sub gingivally Delivered 1.2% Atorvastatin in the Treatment of Chronic Periodontitis in Patients with Type 2 Diabetes Mellitus: A Randomized Controlled Clinical Trial. J. Periodontol. 2016, 87, 1278–1285. [Google Scholar] [CrossRef] [PubMed]
- Tahamtan, S.; Shirban, F.; Bagherniya, M.; Johnston, T.P.; Sahebkar, A. The Effects of Statins on Dental and Oral Health: A Review of Preclinical and Clinical Studies. J. Transl. Med. 2020, 18, 155. [Google Scholar] [CrossRef] [PubMed]
- Pradeep, A.R.; Kumari, M.; Rao, N.S.; Martande, S.S.; Naik, S.B. Clinical Efficacy of Sub gingivally Delivered 1.2% Atorvastatin in Chronic Periodontitis: A Randomized Controlled Clinical Trial. J. Periodontol. 2013, 84, 871–879. [Google Scholar] [CrossRef]
- Bhardwaj, P.; Tripathi, P.; Gupta, R.; Pandey, S. Niosomes: A Review on Niosomal Research in the Last Decade. J. Drug Deliv. Sci. Technol. 2020, 56, 101581. [Google Scholar] [CrossRef]
- Sharma, R.; Due, J.S.; Parsed, D.N. An Overview on Niosomes: Novel Pharmaceutical Drug Delivery System. J. Drug Deliv. Ther. 2022, 12, 171–177. [Google Scholar] [CrossRef]
- Madame, V.B.; Mokale, V.J. Niosomes as an Ideal Drug Delivery System. J. NanoSci. Res. Rep. 2021, 3, 1–9. [Google Scholar] [CrossRef]
- Akbarzadeh, I.; Sedaghatnia, K.; Bourbour, M.; Moghaddam, Z.; Moghtaderi, M.; Samimi-Sohrforozani, E.; Quazi, S.; Far, B. Niosomes: A Novel Targeted Drug Delivery System. Preprints 2021, 2021120315. [Google Scholar] [CrossRef]
- Suchithra, A.B.; Jeganath, S.; Jeevitha, E. Pharmaceutical Gels, and Recent Trends—A Review. Res. J. Pharm. Technol. 2019, 12, 6181. [Google Scholar] [CrossRef]
- Kauslya, A.; Borawake, P.D.; Shinde, J.V.; Chavan, R.S. Niosomes: A Novel Carrier Drug Delivery System. J. Drug Deliv. Ther. 2021, 11, 162–170. [Google Scholar] [CrossRef]
- Bakliwal, S.R.; Rane, B.R.; Jain, A.S. Niosomes and Proniosomes. In A Glimpse of Novel Vesicular Drug Delivery Systems; Nirali Prakashan: Pune, India, 2017; pp. 4.1–4.10. [Google Scholar]
- Ge, X.; Wei, M.; He, S.; Yuan, W.-E. Advances of Non-Ionic Surfactant Vesicles (Niosomes) and Their Application in Drug Delivery. Pharmaceutics 2019, 11, 55. [Google Scholar] [CrossRef] [PubMed]
- Shirisha, N.; Fazal UI Haq, S. Formulation and Evaluation of Mefenamic Acid Niosomal Gel. Res. Rev. J. Pharm. Nanotechnol. 2022, 10, 1–10. [Google Scholar]
- Kamboj, S.; Saini, V.; Bala, S. Formulation and characterization of drug-loaded nonionic surfactant vesicles (niosomes) for oral bioavailability enhancement. Sci. World J. 2014, 2014, 959741. [Google Scholar] [CrossRef]
- Rane, S.; Inamdar, Y.; Rane, B.; Jain, A. Niosomes: A Non-Ionic Surfactant Based Vesicles as a Carriers for Drug Delivery. Int. J. Pharm. Sci. Rev. Res. 2018, 51, 198–213. [Google Scholar]
- Zaid Alkilani, A.; Hamed, R.; Abdo, H.; Swellmeen, L.; Basheer, H.A.; Wahdan, W.; Abu Kwiak, A.D. Formulation and Evaluation of Azithromycin-Loaded Niosomal Gel: Optimization, in Vitro Studies, Rheological Characterization, and Cytotoxicity Study. ACS Omega 2022, 7, 39782–39793. [Google Scholar] [CrossRef]
- Dubey, A. Niosomal Gel of Adapalene: Its Formulation, Physicochemical Properties, and Evaluation for Mild-Acne. Adv. Biomed. Pharm. 2015, 2, 22–31. [Google Scholar] [CrossRef]
- Balouiri, M.; Sadiki, M.; Ibnsouda, S.K. Methods for in Vitro Evaluating Antimicrobial Activity: A Review. J. Pharm. Anal. 2016, 6, 71–79. [Google Scholar] [CrossRef]
- Nalawade, T.M.; Bhat, K.G.; Sogi, S. Antimicrobial Activity of Endodontic Medicaments and Vehicles Using Agar Well Diffusion Method on Facultative and Obligate Anaerobes. Int. J. Clin. Pediatr. Dent. 2016, 9, 335–341. [Google Scholar] [CrossRef]
- Jain, D.V.; Lovanshi, R.; Khan, A.I. Formulation Development and Evaluation of Niosomal Gel of Tazarotene for Treatment of Psoriasis. J. Med. Pharm. Allied Sci. 2021, 10, 2664–2670. [Google Scholar] [CrossRef]
- Abdelbary, G.A.; Aburahma, M.H. Oro-Dental Mucoadhesive Proniosomal Gel Formulation Loaded with Lornoxicam for Management of Dental Pain. J. Liposome Res. 2015, 25, 107–121. [Google Scholar] [CrossRef] [PubMed]
Disclaimer/Publisher’s Note: The statements, opinions and data contained in all publications are solely those of the individual author(s) and contributor(s) and not of MDPI and/or the editor(s). MDPI and/or the editor(s) disclaim responsibility for any injury to people or property resulting from any ideas, methods, instructions or products referred to in the content. |
© 2023 by the authors. Licensee MDPI, Basel, Switzerland. This article is an open access article distributed under the terms and conditions of the Creative Commons Attribution (CC BY) license (https://creativecommons.org/licenses/by/4.0/).







